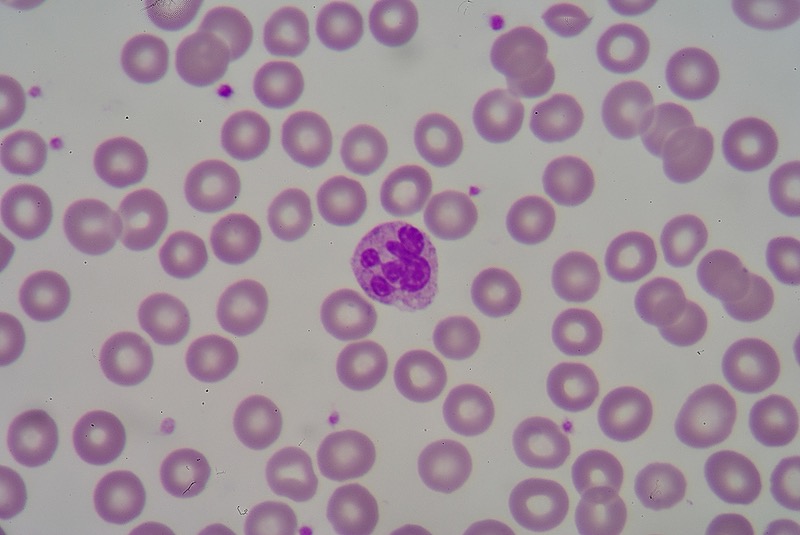

Products
-
Nutritional Blood Analysis - Information & Support
BundleA little more support! These chapters are designed to help empower you as you continue your journey in healthy eating as a support tool in getting you back on track to living the life you love more naturally!
-

Nutritional Wellness Evaluations
CourseThese evaluations are designed to empower you on your wellness journey! Take the evaluation and then interpret your results at the end! Have fun learning more about your nutritional awareness & how to use food as a tool in your wellness routine!
Free
-

Touch For Health Level 4
Course$420
-

Touch For Health Level 3
CourseYou will learn the last of all 42 muscles!! The range of motion, the related meridian/organ system. There will be more correction techniques added, some really fun ones that focus specifically on using color and emotions!
$420
-

The Sugar Shakedown
CourseThe Shake Down On Sugar
Free
-

Touch For Health Level 1
CourseLevel 1 Touch For Health
$483
